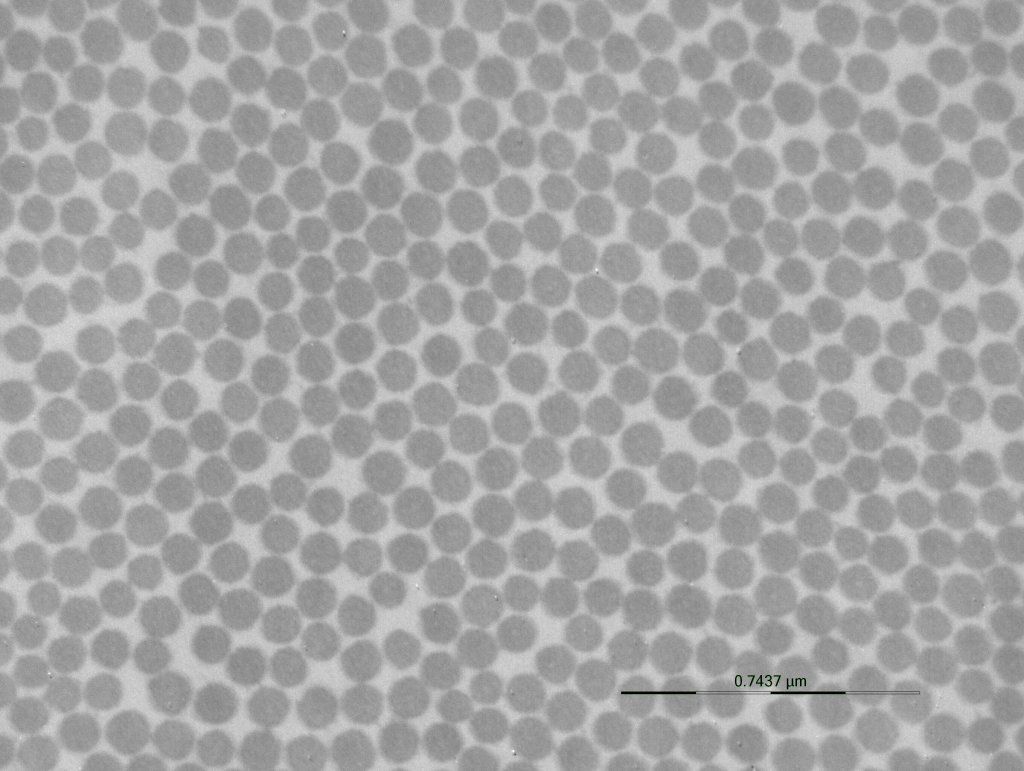
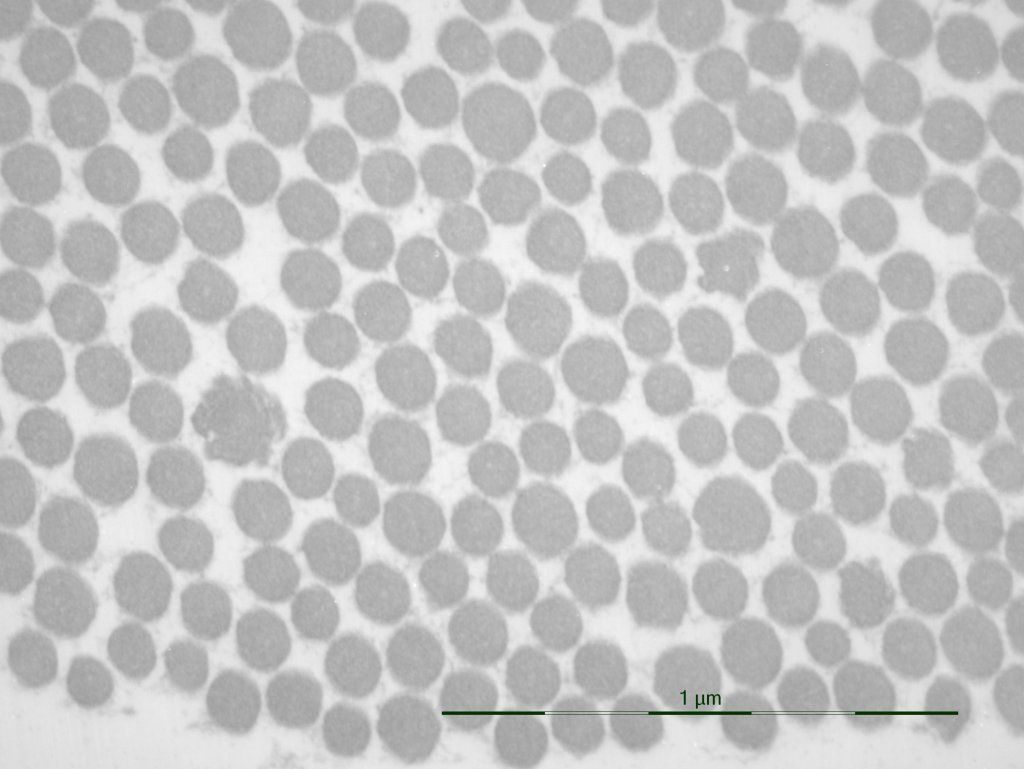

Concernant la biopsie de peau et l'examen ultrastructural du derme en microscopie électronique (ME) :
Mise au point du 19/09/2023 par le Dr Stéphane DAENS
- La Biopsie de peau et son examen en ME présentent une grande sensibilité et une faible spécificité dans le cadre du Syndrome d'Ehlers-Danlos hypermobile (SEDh). En effet, la biopsie de peau montre, le plus souvent, les mêmes anomalies chez les patients hypermobiles asymptomatiques, les patients entrant dans les Désordres du Spectre de l'Hypermobilité et ceux atteints effectivement du Syndrome d'Ehlers-Danlos hypermobile (SEDh).
- Il n'est donc pas utile de faire une biopsie de peau chez tous les patients si l'interrogatoire, les antécédents et l'examen clinique sont en faveur d'un SEDh, et si les Critères de New York 2017 sont validés en faveur d'un SEDh.
- Personnellement, je ne fais actuellement les biopsie de peau que lorsque les patients ont les signes et symptômes du SEDh mais ne sont pas ou plus hypermobile pour une raison ou une autre (arthrose, contractures musculaires diffuses, rétraction musculo-tendineuses réduisant l'amplitude articulaire, etc.), OU lorsque je suspecte un autre sous-type de SED que le SEDh : le SED Classique (+ avis génétique), le SED Vasculaire (+ avis génétique), le SED Cyphoscoliotique (+ avis génétique), ou encore le SED Arthrochalasique ou Dermatosparaxique (très rares, + avis génétique). On peut également voir des anomalies orientant vers une maladie mixte SED/Ostéogenèse Imparfaite (SED/OI).
- Les mutuelles n'ont pas le droit de refuser un accord de kinésithérapie sous prétexte que la biopsie n'a pas été réalisée, alors que les Critères de NEW YORK 2017 sont remplis !
- Les articles qui ont fait suite aux réunions scientifiques de 2016 et qui ont abouti aux Nouveaux Critères insistent sur le fait que le Diagnostic est essentiellement CLINIQUE mais la BIOPSIE de peau, dans certains cas (voir ci-dessus), peut CONFORTER le diagnostic ou l'impression clinique du médecin spécialiste en SED.
- Contrairement à beaucoup de "fake news", la biopsie de peau et la ME sont réalisées dans plusieurs pays y compris la Belgique, la Suisse, l'Allemagne, les Pays Nordiques, etc. La France (ou d'autres pays), par exemple, n'examine pas le derme en ME, la plupart du temps parce que personne n'a été formé à cet examen et/ou n'a suffisamment d'expérience en la matière. Enormément d'articles scientifiques sur le SED comprennent des illustrations en microscopie électronique, le nier est de la mauvaise foi.